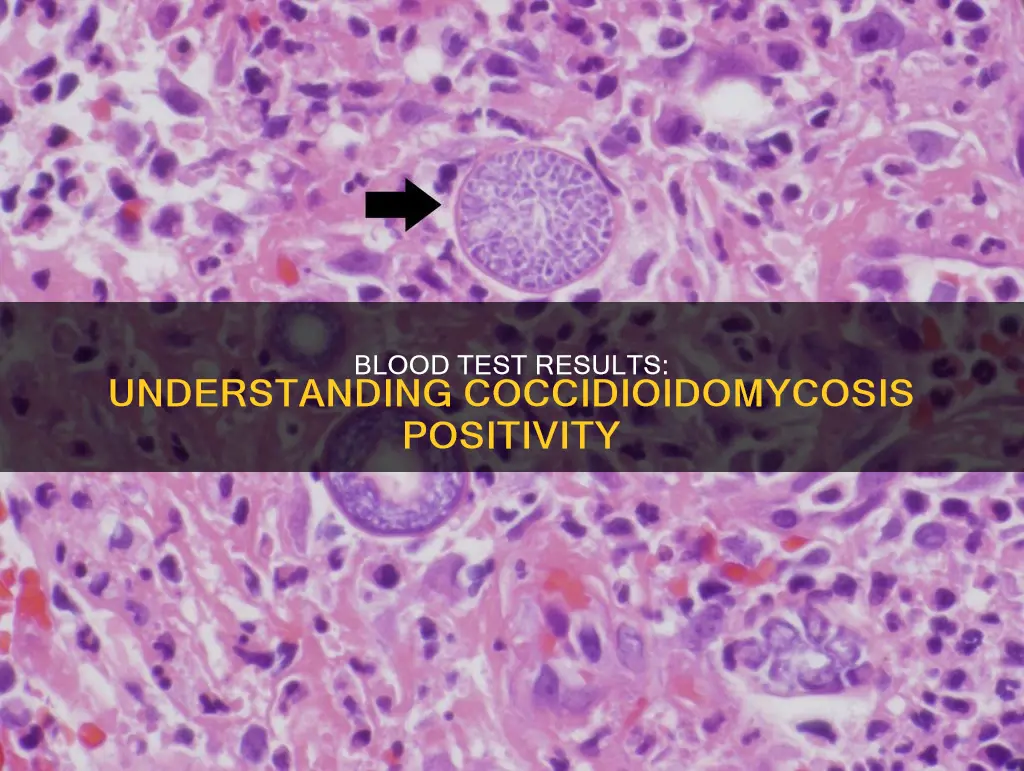
what constitutes a positive blood result for coccidioidomycosis

Coccidioidomycosis, or Valley Fever, is an invasive fungal disease that often presents as pneumonia. It is commonly misdiagnosed and mistreated with antibiotics. The diagnosis of coccidioidomycosis is established by observing Coccidioides in a clinical specimen. The detection of antibodies to coccidioidal antigens has been used to diagnose the disease and monitor patients undergoing therapy. Serologic tests for coccidioidomycosis measure titers of immunoglobulin M (IgM) or immunoglobulin G (IgG). The appearance of IgM is the most sensitive serologic indication of early infection. The IgM antibody fades over several weeks and dissipates within 6 months in most patients. The ID IgG was configured to more sensitively detect the same antibodies that produce a positive CF antibody test. The most sensitive testing option for coccidioidomycosis is a combination of tests for antibodies including the MiraVista IgG EIA (MVista® Cocci IgG) and Immunodiffusion (Cocci ID).
| Characteristics | Values |
|---|---|
| Test Type | Enzyme immunoassay (EIA), Immunodiffusion (ID), Complement Fixation (CF), Polymerase chain reaction (PCR), Antigen detection, Microscopy and culture of respiratory specimens from a bronchoscopy |
| Test Purpose | To detect specific antibodies in a patient's serum |
| Antibodies Detected | Immunoglobulin M (IgM), Immunoglobulin G (IgG) |
| Positive Result Indication | Active infection likely present |
| Negative Result Indication | Does not exclude diagnosis, repeat testing may be necessary |
| False Positives | Rare |
| False Negatives | Possible |
| Test Sensitivity | Depends on test type and combination, can be >&98% |
| Test Specificity | Depends on test type and combination, can be >97% |
| Test Limitations | Antigen testing alone lacks sensitivity, antibody testing does not indicate infection |
| Test Costs | N/A |
| Test Turnaround Time | N/A |
Explore related products
What You'll Learn

False positives and negatives
False negatives are possible with enzyme immunoassay (EIA) tests, particularly with IgM. If the EIA IgM is reactive, it could be a false positive, and repeated testing may be required. False negatives are also possible, and if clinical suspicion remains, repeat serology may be considered 2-6 weeks after the initial test. If the patient is immunosuppressed or the illness is progressing rapidly, microscopy and culture of respiratory specimens from a bronchoscopy may be necessary. Polymerase chain reaction (PCR) and antigen detection can also be helpful.
The sensitivity of serologic tests is modest, and negative results can delay diagnosis and treatment. False negatives are more likely in immunosuppressed patients, who may have lower rates of seropositivity. In such cases, combining different test results can increase sensitivity.
In endemic areas, false positives are a concern due to the higher likelihood of prior pulmonary infection. This can lead to unnecessary further diagnostic procedures, which can be risky for patients.
The complement fixation test is also not a definitive confirmation of Valley Fever, as not all patients develop detectable coccidioidal complement fixation titers. However, false positives are rare, and a positive serologic result is likely to be clinically relevant.
The Constitution: Building a More Perfect Union
You may want to see also
Explore related products

Immunodiffusion and complement fixation
Coccidioidomycosis, also known as Valley Fever, is a fungal infection found in the Southwestern US, Central America, and South America. It is caused by the inhalation of Coccidioides immitis/posadasii. The diagnosis of coccidioidomycosis involves various laboratory tests, including immunodiffusion and complement fixation.
Immunodiffusion
Immunodiffusion is a serum-based diagnostic test used to identify specific antibodies in a patient's serum. The test relies on the ability of antibodies and antigens in different wells of a gellan plate to diffuse into the gel and form a visible precipitation band at their intersection point. This test is highly sensitive for the detection of Coccidioides-specific antibodies, particularly IgM (also known as coccidioidal precipitins) and IgG antibodies. The presence of these antibodies indicates an active infection or a recent asymptomatic infection.
Complement Fixation
Complement fixation (CF) is another serum-based test that quantifies the amount of specific IgG antibody in a patient's serum. The test involves incubating patient serum with coccidioidal antigen and complement. If the patient's serum contains IgG antibodies specific to coccidioidal antigens, the resulting mixture will not lyse red blood cells, indicating a positive result. Conversely, if the patient's serum does not contain these antibodies, the mixture will lyse red blood cells, resulting in a negative result. The CF titer is determined by diluting the serum and finding the highest concentration that prevents red blood cell lysis.
Over 90% of primary symptomatic cases of coccidioidomycosis will be detected by combining immunodiffusion and CF testing. These tests are valuable tools for diagnosing and monitoring Valley Fever, providing sensitive and specific results. However, it is important to consider the experience of laboratory staff in interpreting the results, as false positives and negatives can occur.
In summary, immunodiffusion and complement fixation play crucial roles in the detection of specific antibodies associated with coccidioidomycosis. These tests help diagnose and monitor the disease, contributing to effective patient management.
The Commonwealth of Australia: How Many Countries Unite?
You may want to see also
Explore related products

EIA tests for IgM and IgG antibodies
The EIA test for IgM and IgG antibodies is a sensitive but non-specific test that can be used to detect the presence of antibodies against coccidioidal antigens, which are indicative of coccidioidomycosis, also known as Valley Fever.
The test works by detecting the presence of IgM and IgG antibodies in the patient's serum or blood. IgM antibodies are the first to be produced by the body when exposed to a new infection, providing short-term protection while the body generates other antibodies. They are usually detectable within the first week of infection and in about 90% of cases by the third week. However, they start to fade and are typically no longer detectable after 6 months. IgG antibodies, on the other hand, are more common and specialized. They are produced in response to specific germs, and the body remembers them even after clearing the infection. This allows the immune system to quickly produce more antibodies if exposed to the same germ again.
In the context of coccidioidomycosis, a positive EIA test for IgM and/or IgG antibodies suggests the presence of an active infection. If only the EIA IgM test is positive, there is a possibility of a false-positive result, and repeat testing may be warranted. A negative EIA test for both IgM and IgG antibodies does not completely exclude the diagnosis of coccidioidomycosis, and repeat testing is recommended.
It is important to note that the EIA test alone is not sufficient for diagnosing coccidioidomycosis. Other tests, such as immunodiffusion and complement fixation, are also used in conjunction with the EIA test to confirm the presence of the disease. Additionally, the patient's clinical presentation and the clinician's suspicion are also taken into account when establishing a diagnosis.
Dividing Power: The Constitution's Two Key Methods
You may want to see also
Explore related products

Treatment after a positive result
Once a positive diagnosis of coccidioidomycosis (Valley fever) is established, clinicians should refer to the Infectious Diseases Society of America's coccidioidomycosis treatment guidelines or consult a specialist in infectious diseases when selecting therapy. This is an invasive fungal disease that often presents as community-acquired pneumonia and is commonly misdiagnosed and inappropriately treated with antibiotics.
If a patient has a positive EIA test, clinicians may consider follow-up testing with ID and CF to rule out false positives and confirm the diagnosis. In highly endemic areas or with highly suggestive clinical findings, clinicians might start managing pulmonary coccidioidomycosis while awaiting results from ID or CF. If the follow-up testing with ID or CF is negative, consider repeat ID or CF to rule out false negatives.
The UC Davis Coccidioidomycosis Serology lab performs coccidioidal immunodiffusion and complement fixation, which comprise a sensitive and specific repertoire for Valley Fever diagnosis and disease monitoring. Immunodiffusion is a serum-based diagnostic that identifies specific antibodies in a patient’s serum. The test relies on the ability of antibodies and antigens in different wells of a gellan plate to diffuse into the gel and form a visible precipitation band at their intersection point. When performed in an experienced lab, this test is highly sensitive for the detection of Coccidioides-specific antibodies and thus the diagnosis of Valley Fever.
Serologic tests for coccidioidomycosis measure titers of immunoglobulin M (IgM) or immunoglobulin G (IgG). These tests can also be performed on cerebrospinal fluid (CSF) upon suspicion of coccidioidal meningitis. The appearance of IgM or precipitin antibody against Coccidioides is the most sensitive serologic indication of early infection. IgM is detected in approximately half of all coccidioidal infections within the first week and in about 90% by 3 weeks. The IgM antibody fades over several weeks and, in most patients, these antibodies dissipate within 6 months.
In areas endemic for coccidioidomycosis, prior pulmonary infection may account for 25–50% of solitary pulmonary nodules. As patients undergoing CT screening all have an increased risk for lung cancer, any identified nodules would typically undergo further diagnostic workup.
Congressional Powers: What the Constitution Doesn't Allow
You may want to see also
Explore related products

Testing algorithms
Specific laboratory tests for coccidioidomycosis include the detection of antibodies to coccidioidal antigens, which has been the standard for diagnosis and monitoring of the disease for over half a century. Serologic tests for coccidioidomycosis measure titers of immunoglobulin M (IgM) or immunoglobulin G (IgG). These tests can also be performed on cerebrospinal fluid (CSF) if coccidioidal meningitis is suspected. The appearance of IgM is the most sensitive serologic indication of early infection, with IgM detected in approximately half of all coccidioidal infections within the first week and in about 90% by three weeks. However, IgM may persist or reappear in certain circumstances, such as chronic cavitary coccidioidomycosis or systemic reinfection.
The ID IgG test is configured to detect the same antibodies that produce a positive CF antibody test, and a negative ID IgG test result should make further CF antibody testing unnecessary. However, this relationship depends on the laboratory staff's training and experience in reading ID plates, and some authorities recommend CF antibody testing for all sera that are EIA reactive. Once a diagnosis of coccidioidomycosis is established, only the CF antibody test should be used for ongoing management, as none of the other tests have prognostic value.
The most sensitive testing option for coccidioidomycosis is a combination of tests for antibodies, including the MiraVista IgG EIA (MVista® Cocci IgG) and Immunodiffusion (Cocci ID), which provides a sensitivity of >98% while remaining highly specific (97%). An alternative combination with high sensitivity (>93%) includes testing for antibody with the MVista® Cocci IgG and for antigen with the MiraVista Coccidioides urine antigen EIA (MVista® Cocci Ag). Antigen testing alone lacks sensitivity, but when positive, it can guide treatment monitoring, as can antibody testing.
If the EIA test is positive, clinicians may consider follow-up testing with ID and CF to rule out false positives and confirm the diagnosis. If the follow-up testing with ID or CF is negative, consider repeating ID or CF to rule out false negatives. If the initial EIA test is negative, clinicians should consider alternative diagnoses. However, if clinical suspicion remains high, illness progression occurs, or symptom onset was recent, repeat serology may be considered 2 to 6 weeks after the initial EIA test, or consultation with a specialist in infectious diseases or a pulmonologist.
Robocalls: When Do They Become Harassment?
You may want to see also
Frequently asked questions
Coccidioidomycosis is an invasive fungal disease that often presents as community-acquired pneumonia. It is commonly referred to as Valley Fever.
Coccidioidomycosis is diagnosed through a combination of tests for antibodies, including the MiraVista IgG EIA (MVista® Cocci IgG) and Immunodiffusion (Cocci ID). This combination provides a sensitivity of >98% while still being highly specific (97%).
A positive blood result for coccidioidomycosis indicates the presence of antibodies specific to Coccidioides. This can be detected through immunodiffusion and complement fixation tests, which are highly sensitive and specific for Valley Fever diagnosis.
If you test positive for coccidioidomycosis, clinicians will consider follow-up testing with ID and CF to rule out false positives and confirm the diagnosis. Treatment options should be discussed with a specialist in infectious diseases.








































